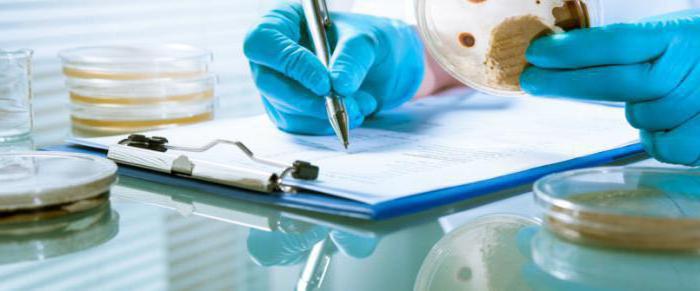
preventive disinfection station

Disinfection refers to complex measures that are used to destroy pathogenic and conditionally pathogenic microorganisms. The importance of disinfection was recognized back in the Middle Ages, when terrible epidemics of infectious diseases began. It was then that a variety of disinfectants appeared, instructions and rules were developed.
Initially, only focal disinfection was carried out, but subsequently, preventive disinfection became a priority, carried out as a preventive measure in the absence of the disease.
Purpose and types of preventive disinfection
The main goal of preventive disinfection is to prevent the emergence of infectious diseases in order to form and maintain safe living conditions. 
To date, there are several types of destruction of pathogenic microbes. The main ones are preventive and ongoing disinfection, as well as final disinfection measures. The last two species relate to focal disinfection.
Preventive disinfection is carried out in order to prevent infection where pathogens can appear. These are medical, educational institutions, food industry enterprises, public places, water and sewage treatment plants, etc. This type of disinfection does not depend on the epidemiological situation and the presence of pathogens.
Conducting preventive disinfection is possible both on their own (by the institution), and by specialized services. Regulatory documents regulate this disinfection.
Allocate planned and unscheduled preventive disinfection. Another type of preventive disinfection is mechanical hand disinfection and surface treatment at home. These measures are aimed at reducing the likelihood of infection.
Current disinfection destroys the source of infection, the pathogens themselves and prevents the spread of infections.
The final measures include disinfecting things of patients, household items, which can be a source of infection.
Prophylactic Disinfection Methods
Today, there are 4 main methods of disinfection:
- Mechanical. Cleaning surfaces, air, water is carried out mechanically. This includes air filtration, surface cleaning, washing, ventilation, water filtration and more.
- Chemical. In this case, various disinfectants are used that kill pathogens and destroy toxins. In general, preventive chemical disinfection involves the use of chlorine and alcohol products, hydrogen peroxide, formalin.
- Physical. It involves physical exposure, which is the processing of materials by high temperatures or ultraviolet radiation. This method is effective and environmentally friendly.
- Biological. In this case, various microorganisms interact. As a rule, sewer and sewage are disinfected by this method, and septic tanks and drains are cleaned.
To increase the effectiveness of the result, very often these methods are combined with each other. 
Preventive Disinfection Rules
The rules for disinfection are distinguished by objects, area, method and level of disinfection and establish them after a thorough study. They describe in detail about the procedure, method of conduct, disinfectants and specialized equipment.
The disinfection rules, which are established by various surveillance authorities, tell about all areas of activity where pathogenic and opportunistic organisms can spread, and where preventive disinfection must be carried out. General provisions usually indicate how to properly disinfect the premises, process and sterilize special-purpose products, explain the rules of staff work and the correct storage of sterile instruments. 
Prophylactic Disinfection
There are various disinfectants. They are divided according to the form of release and purpose. Basic requirements for disinfectants:
- high efficiency, which provides targeted impact in a short time;
- security;
- means should be compatible and harmless to the processed products and surfaces;
- specialized cleaning of any contaminants;
- stable use;
- possible control of the concentration of funds in solution, etc.
To date, the Department of State Sanitary and Epidemiological Supervision of the Ministry of Health of the Russian Federation has authorized the use of about 250 different disinfectants. All of them have certificates.
Solution and tablets for disinfection
Preventive disinfection agents are usually available in the form of a solution and tablets.
The solution for disinfection perfectly destroys dangerous microorganisms on objects, tools, surfaces. Often this tool is mistaken for an antiseptic solution, which processes the skin and cavities of the human body. And here these concepts are not always separated, since instruments can be disinfected with some antiseptics, and vice versa, skin can be treated with some disinfectant solutions.
Typically, disinfectant solutions are based on the following groups of substances:
- halogens and halogen-containing compounds;
- oxidizing agents;
- alcohols and aldehyde compounds;
- metal salts;
- phenols.
Also in solutions, these compounds can be combined.
Of course, some solutions need to be handled carefully, protecting the skin, mucous membranes and respiratory tract, as well as ventilating the treated rooms.
Pills for prophylactic disinfection is a specialized disinfectant, dry, dosed and shaped. It is intended to destroy pathogenic microflora. Dry disinfectant reagent can be produced both in the form of tablets, and in the form of granules. 
Disinfection stations
Disinfection, as a rule, is carried out by specialized organizations-disinfection stations (centers). Preventive disinfection station is a sanitary and anti-epidemic institution that performs various disinfection measures that prevent the occurrence of infections and eliminate foci of infection. Such stations are created in cities or large settlements. They work both under contracts with organizations and at the request of the population.
In addition to carrying out preventive disinfection, such organizations register and account for infectious patients, disinfect things in special chambers, etc.
Also, the center for preventive disinfection exercises control over various disinfection works, for medical institutions, kindergartens, schools, etc.
Medical and home disinfection
Depending on the venue, medical and home preventive disinfection are distinguished.
Under medical disinfection is understood a complex of disinfecting measures, which is carried out in specialized institutions. Ongoing actions kill pathogens and prevent the spread of infection.
Preventive disinfection at home is carried out both by special services and independently.If there are infectious patients at home, then disinfection should be carried out by medical services with special equipment. When carrying out preventive home disinfection, one's own strength is usually enough. 
There are several ways to disinfect your home:
- partial. It is carried out daily (they wash their hands, process food, wash, dust, air, wash the floor).
- complete. In this case, the chemical and mechanical disinfection methods are combined. It’s good to add a physical method of processing ultraviolet radiation. Preventive disinfection of premises can be carried out with disinfectants. Soft toys, carpets, mattresses, upholstered furniture are treated with soap solutions.
When carrying out home preventive disinfection, one should not forget about safety measures (glasses, gloves, a respirator, a mask).
Hand disinfection
Preventive hand disinfection protects the body from pathogens and the spread of infectious diseases. Thus, the likelihood of infection of the subject is reduced. 
There is household, hygienic and surgical hand disinfection.
Hand treatment should be carried out according to a general standard that describes the procedure: movements, antiseptic agents, wiping hands, closing the tap, etc.
Household preventive hand disinfection is carried out mechanically without antiseptic agents. In the household method, hands are washed with soap and rinsed in running water.
Hygienic hand disinfection is carried out with antiseptic agents that remove pathogenic or conditionally pathogenic microflora. Hygienic disinfection, as a rule, is combined with a household method.
The surgical method is used during surgical operations.
Water disinfection
Preventive disinfection of water is aimed at disinfecting water and cleaning it from microorganisms.
There are several types of water disinfection:
- reagent;
- reagentless;
- combined.
Reagent disinfection is chlorination, ozonation, silvering, iodination, bromination and treatment with chlorine dioxide.
Reagent-free disinfection is the treatment with ultraviolet and ultrasound.
The combined method is carried out either by two types of disinfection, or by two different reagents.